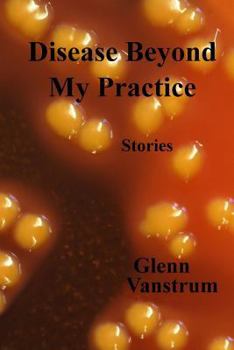
Paperback Disease Beyond My Practice Book

Disease Beyond My Practice
No one can survive a bi-polar world without a healthy dose of madness. An infectious disease doctor falls in love with a dope addict/real-estate agent. A paranoid schizophrenic decides he must render... This description may be from another edition of this product.
Format:Paperback
Language:English
ISBN:1482748215
ISBN13:9781482748215
Release Date:March 2013
Publisher:Createspace Independent Publishing Platform
Length:252 Pages
Weight:0.75 lbs.
Dimensions:0.5" x 6.0" x 9.0"
Customer Reviews
0 rating